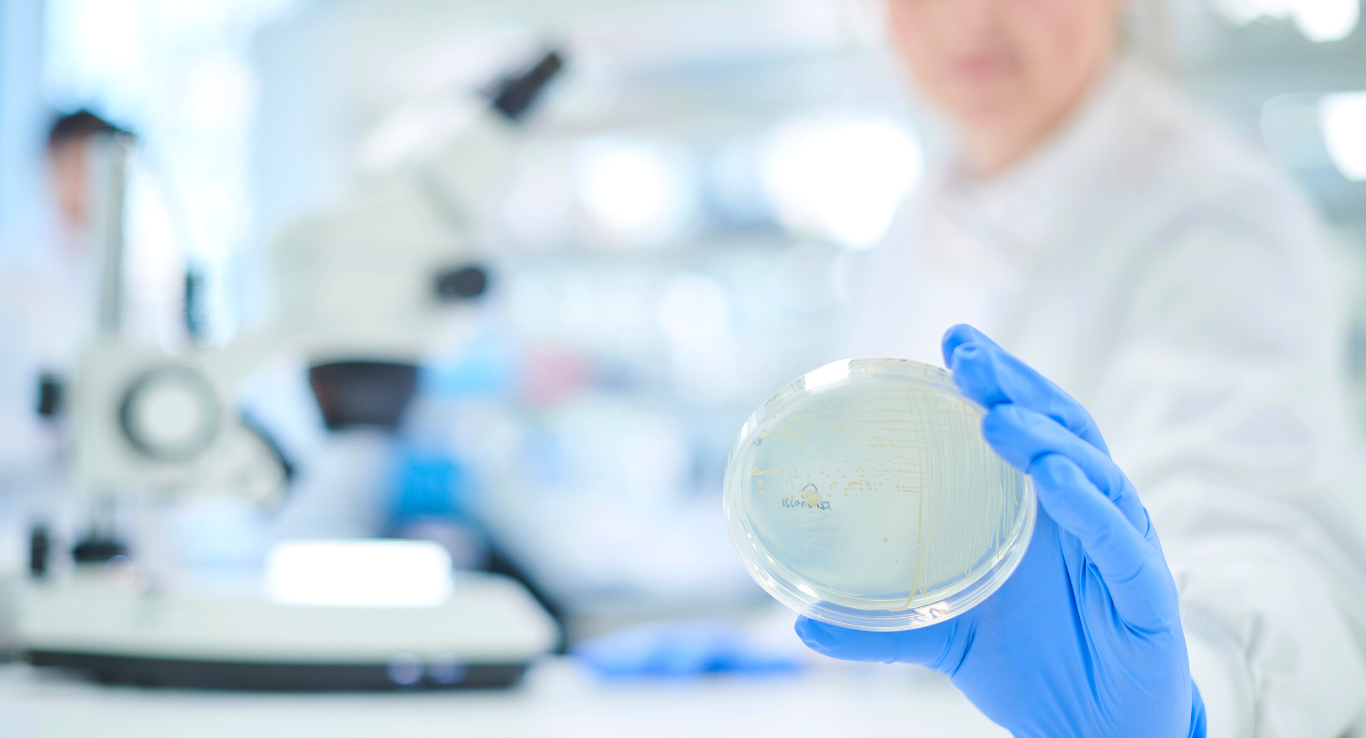

Antimicrobial Resistance (AMR) occurs when germs, such as bacteria and fungi, no longer respond to drugs designed to kill them. As such, these ‘superbugs’ undermine modern medicine and increase the risk of death from currently treatable infections.
AMR Commercialisation 101 is an opportunity for participants to gain a foundational understanding of how to validate an AMR-mitigating idea, identify unmet market needs, undertake customer analysis and hear from a number of Australian businesses operating in adjacent areas.
The course will equip participants with the knowledge and skills to begin commercialising new products that can make a significant impact on improving human, animal and environmental health.
Participants will hear insights from Australian companies including Cochlear, SpeeDx, Hexima, Bioproperties and Dose Me.
As seen in Innovation Aus: Read about how the pipeline for new “superbug” treatments is running dry

.png)